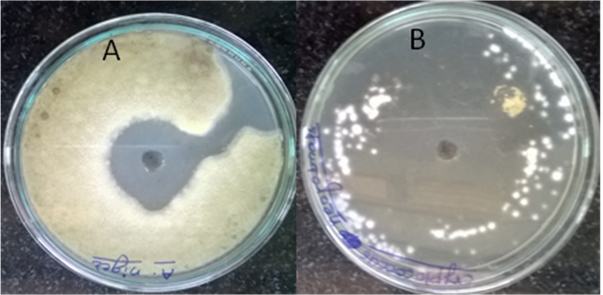

Int J Pharm Pharm Sci, Vol 8, Issue 2, 307-311Original Article
ANTIOXIDANT, ENZYME INHIBITORY AND ANTIFUNGAL ACTIVITIES OF ACTINOMYCETES ISOLATED FROM CURCUMA LONGA RHIZOSPHERE
HEMLATA BHOSALE*, PRITI BISMILE, TUKARAM KADAM, UZMA SHAHEEN
DST-Fist Sponsored School of Life Sciences, Swami Ramanand Teerth Marathwada University, Nanded, M. S., India 431606
Email: bhoslehemlata@gmail.com
Received: 11 Sep 2015 Revised and Accepted: 13 Jan 2016
ABSTRACT
Objective: To screen the actinobacterial strains associated with root rhizosphere of Curcuma longa for antioxidant, enzyme inhibitory and antifungal potential and to identify the potent strain TRA-1.
Methods: The strains were isolated on starch casein agar (SCA). The antioxidant, enzyme inhibitory and antifungal activities were studied using standard methods. Identification of active strain TRA-1 was carried out by studying morphological and cultural characteristics and by employing 16S rRNA sequencing.
Results: The detected phenolic content and total antioxidant activities were in the range of 1µg/ml to 80 µg/ml and 0.198 to 1.088 each. Diphenyl picrylhydrazyl (DPPH) and hydroxyl radicals scavenging activity and capacity to chelate metal ion and reduce ferric iron were found in 11, 14, 6 and 12 strains respectively. The activities of α-amylase and α-glucosidase were inhibited by crude extracts of twelve and three isolates and the extracts of ten isolates inhibited lipase activity. Nine isolates inhibited the growth of one or more test fungal pathogens. All test pathogens were sensitive to TRA-1. The active strain TRA-1 was identified as Streptomyces albus. The active metabolite of TRA-1 showed 41.43% DPPH scavenging activity, 54.48% and 34.46% respective inhibition in α-amylase and lipase activity and was highly active against C. neoformans (35 mm) followed by A. niger (18 mm).
Conclusion: The results of the study showed remarkable antioxidant, enzyme inhibitory and antifungal potential of isolated strains. The potent strain Streptomyces albus TRA-1 can be used as a promising source for isolation of pharmaceutically important bioactive compounds.
Keywords: Antioxidant, Inhibition, Enzyme, Antifungal, Streptomyces albus.
© 2016 The Authors. Published by Innovare Academic Sciences Pvt Ltd. This is an open access article under the CC BY license (http://creativecommons.org/licenses/by/4.0/)
INTRODUCTION
In past few decades, the search for natural products derived from plants, animals and microorganisms has been intensified due to their applications in the treatment of numerous human related diseases. So far, more than a million natural products have been discovered by using various drug screening programs. More than 22,500 bioactive compounds have been extracted from microorganisms and among these, actinomycetes derived products contributes a major share (45%) followed by fungi (38%) and unicellular bacteria (17%) [1].
Actinomycetes are the most ecologically and biotechnologically valuable prokaryotes being responsible for the production of about half of the discovered bioactive metabolites including antibiotics [2], antitumor and immunosuppressive agents [3] and enzymes [4]. Recently, the antioxidant and anti-diabetic activities of secondary metabolites isolated from Streptomyces and Nocardiopsis species have been reported [5]. Streptomyces sp are known as most promising candidates as they are producers of about more than 80% of secondary metabolites identified from actinomycetes. However, the immense biotechnological potential of actinomycetes has led to extensive search on isolates from normal terrestrial habitats and resulted in an associated increase in the number of compounds being rediscovered due to a high rate of redundancy in the strains isolated [6]. A mathematical model designed to estimate the number of undiscovered antimicrobial agents from the genus Streptomyces predicts that the decline of finding such agents is due to the declining efforts in screening more microorganisms and not due to a lesser number of undiscovered antimicrobial agents [7] and thus, the search for microorganisms and new bioactive compounds has gained importance. In this regard, the root rhizosphere soil of medicinal plants could be a better option of environment for isolation of actinomycetes with new biologically active metabolites.
Curcuma longa (Turmeric), categorized under Zingiberaceae family, is one of the important spice crops in India and extensively used as therapeutic agent for over 6000 y in Ayurveda, Unani and Siddha medicinal systems. Rhizome portion of C. longa (L) is used as an antiseptic, antileukemic, and antihelminthic, anti bronchitic, candidicidal agent, as CNS stimulant, fungicide, pesticide and also shows antitumor, antiaging, antioxidant and antimutagenic activities. The characteristics of rhizome to display all these activities is due to the presence of an array of chemical substances including, cineole, hydroxymethyl anthraquinone, terpinol, turmerone, ascorbic acid, azulene, caffeic acid, caprylic acid etc. These substances are expected to be released in some extent during rhizodeposition and provide important substrates for the growth of associated soil microbial community. The microorganisms which are resistant to these substances are able to metabolize them during their growth and are expected to produce novel bioactive compounds.
Oxidative stress is a deleterious process generated due to excess production of reactive oxygen species [ROS] and plays important role in development of vascular complications in diabetes particularly in type II diabetes [8]. Under these situations the patients exhibits lower immune response, making them immunocompromised. Hence, apart from metabolic acute complications and systemic late complications, onset of many infections caused by opportunistic pathogens is commonly observed in patients suffering from diabetes. The synthetic antioxidants such as butylated hydroxy anisole (BHA) and butylated hydroxy toluene (BHT) are known to induce carcinogenic effects in living cell. The knowledge regarding emergence of new diseases and multiple drug resistance to human pathogenic bacteria and fungi, toxic nature of ROS, harmful side effects associated with available synthetic drugs and complications raised due to diabetes, have opened a new vista for the search of new antiradical, antidiabetic and antimicrobial agents from natural sources. The present research work describes isolation of actinomycetes from root rhizosphere of C. longa (L) and their screening for antioxidant, enzyme inhibitory and antifungal activities. The identification of potential actinomycete strain is also reported.
MATERIALS AND METHODS
Sample collection and isolation of actinomycetes
Rhizospheric soil was collected from the agricultural field having previous 15 y history of turmeric cultivation in Nanded, M. S. India. Briefly the plants were uprooted and the soil adhered to roots was collected in sterile polyethene bags and stored at 4 oC until processed. For the isolation of actinomycetes, 10 g oven dried soil was suspended in 90 ml of sterile distilled water and used for preparing tenfold serial dilution. 0.1 ml of each dilution (10-3 to 10-7) was spread in triplicates on SCA plates [9] supplemented with 50 µg/ml of each nystatin, cyclohexamide and tetracycline. The plates were incubated at 30±2 ºC for 7 d and fourteen morphologically distinct, well-isolated colonies of actinomycetes were selected for further study.
Source of bioactive substance from actinomycetes
Briefly, the selected actinomycetes were grown individually in soybean casein digest broth supplemented with 1% dextrose (Hi Media) on rotary shaker at 30 oC and 120 rpm for 7 d. After incubation, the broths were centrifuged at 10,000 rpm for 30 min at 4 oC. The supernatants were used as a crude source of metabolites from respective actinomycetes and tested for the presence of a compound with biological activity.
Screening of actinomycetes for antioxidant properties
The selected crude extracts of actinomycetes were screened for antioxidant compounds by using DPPH radical scavenging assay [10], determining total phenol content [11], total antioxidant activity [12], hydroxyl radical scavenging activity [13], ferrous reducing assay [14] and assay for metal chelation capacity [15]. Ascorbic acid was used as a standard antioxidant for DPPH, total antioxidant activity and hydroxyl radical scavenging assay, phenolic contents were determined using catechol as a standard and tannic acid and EDTA were used as positive controls for ferrous reducing assay and metal chelation assay respectively.
Screening of actinomycetes for presence of enzyme inhibitors
The in vitro α-glucosidase inhibition assay was used to test the inhibition activity of selected actinomycetes [16]. The assay mixture consisted of 100 µl phosphate buffer (0.1 M, pH 7.2), 100 µl p-Nitrophenyl-β-D-glucopyranoside (5 mM in 0.1M phosphate buffer, pH 6.9) and the 500 µl crude extract from different actinomycetes. The reaction was initiated after 5 min preincubation of assay mixture at room temp by adding the crude α-glucosidase solution from yeast (25 µl). This was followed by 10 min incubation at 28 oC. After incubation, the absorbance was recorded at 405 nm on microtitre plate reader and compared with the control (phosphate buffer solution in place of the crude extract). Acarbose was used as standard α-glucosidase inhibitor, and the intensity of inhibition (%) was calculated as follows:

Where, A is the absorbance of control at 405 nm and B is the absorbance in the presence of extract.
The assay mixture used for detecting the presence of α-amylase inhibitors involves 500 µl crude extracts of each isolate and 500 µl sodium phosphate buffer (0.02 M, pH 6.9) containing α-amylase solution (0.5 mg/ml). The reaction was initiated after pre incubation of 10 min at 37 oC by adding 500 µl starch (1% in 0.02 M phosphate buffer, pH 6.9). The whole reaction mixture was incubated for 10 min at 37 oC and the reaction was terminated by adding 1 ml dinitro salicylic acid reagent. The tubes were kept in boiling water bath for 5 min and cooled to room temp. The rate of inhibition was calculated by noting the amount of glucose released at 540 nm in presence and absence of extracts [17]. Acarbose was used as a standard α-amylase inhibitor and inhibition was determined as follows:
![]()
Where, A is the absorbance of control at 540 nm and B is the absorbance in the presence of extract.
Lipase inhibitory activity of crude extracts were tested by mixing 1000 µl of each extract, 3 ml of olive oil emulsion (5% olive oil emulsified with 10% gum arabic) and 1 ml lipase (from A. niger, Hi Media) solution (1.56 mg/ml) followed by 30 min incubation at 37 oC. The control was prepared by replacing crude extract with phosphate buffer from the reaction mixture. The fatty acids liberated were estimated by titrating contents of reaction mixture against 0.05 M NaOH and using phenolphthalein (0.1% ethanolic) as pH indicator [18]. Lipase inhibition activity (%) of extracts was calculated as follows:

Where, A is the enzyme activity in control and B is the activity in the presence of extract.
Screening of actinomycetes for antifungal activity
Antifungal activity of crude extracts of selected actinomycetes was assessed by performing agar well diffusion assay. The test fungi (Aspergillus niger, Aspergillus flavus, Cryptococcus neoformans and Trichophyton rubrum) availed from School of life sciences culture facility centre, S. R. T. M. University Nanded, were inoculated in antifungal assay broth (Hi Media) and incubated for 48 h at 30 oC. 0.1 ml of active culture of each test fungus was spread on the surface of sterile potato dextrose agar and wells of 5 mm were made using sterile cork borer. 100 µl crude extract of each isolate was transferred into wells, and the plates were kept for incubation at 30 oC for 48–72 h. Nystatin (50 µg/ml) was used as positive control. Each test was performed in triplicate and antifungal activity was expressed as the mean of the diameter of zone of inhibition formed around the wells.
Identification of potential bioactive compound producer strain
The strain TRA-1 showing good antioxidant, enzyme inhibitory and antifungal activities was selected as a potential strain and was identified based on morphological characterization and using 16S r RNA sequencing. The inclined cover slip culture technique was adapted to study morphological and sporulation pattern of TRA-1 on SCA after growing at 30 oC for 7 d. National Bureau standards (NBS) colour name charts were used to record the colour of spore mass and aerial and substrate mycelia [19]. Chemotaxonomic studies relating type of amino acids and sugar content present in whole cell hydrolysates were performed as mentioned earlier [20, 21]. The strain TRA-1 was identified at the molecular level by 16S rRNA sequencing after isolating the DNA using phenol-chloroform extraction method. The primers used for PCR analysis were 8 F: 5’AGAGTTT GATCCTGGCTCAG-3’ and 907 R: 5’CCGTCAATT CMTTTRAGTTT-3’. The PCR amplification conditions used for the study were 94 oC for 3 min, 53.2 oC for 50 s, 72 oC for 60 s and final extension step of 71.5 oC for 3 min. The PCR product was purified by PEG-NaCl method and sequenced on ABI 3730XL sequencing machine. The forward and reverse sequences were assembled through DNA Baser V35.0 software and aligned with other closely related taxa retrieved from GenBank database. Comparison of 16 S ribosomal RNA gene sequence of TRA-1 and other known bacterial sequences was done using NCBI BLASTn. The reference sequences required for comparison were downloaded from http://www. ncbi. nlm. nih. gov/gene bank. The sequence alignment was done by using CLUSTAL W, a multiple sequence alignment programs, gaps were removed manually and pairwise evolutionary distances were computed using the Kimura 2-parameter model [22]. The bootstrap analysis was done using 1000 replicates of original dataset and used for constructing the phylogenetic tree using Neighbor-joining method [23].
RESULTS AND DISCUSSION
Root rhizosphere soil is nutritionally rich niche providing different growth factors to associated microflora. Isolation of various groups of actinomycetes from the rhizosphere of different plant species have been reported previously [24]. Turmeric is an important member of Zingiberaceae family that have proved its immense potential in treating various ailments and has antitumor, anti aging, antioxidant and antimutagenic activities. In the present study, 14 strains of actinomycetes isolated from root rhizosphere of C. longa were selected for screening various biological activities.
Antioxidant activities of actinomycetes
Radical scavenging ability of antioxidant compounds was evaluated extensively by using stable free radicals containing DPPH molecule. Of the total isolates selected for study, ten showed DPPH scavenging activity and was found in a range of 12.15% to 69.88 %. The strain TRA-3a showed the highest scavenging activity whereas it was least found in strain TRA-30. However, the recorded activities of all strains were lower than the ascorbic acid (100 µg/ml, 87.83%) which was used as a standard antioxidant compound. (fig. 1)

Fig. 1: DPPH radical scavenging activity of actinomycetes isolated from C. longa root rhizosphere. Each value represents mean±standard deviation (SD) of three independent replicates. Error bar indicates SD
The results on detected phenol content and total antioxidant activities in crude extracts of selected actinomycetes are shown in fig.2. The antioxidant properties of bioactive compounds are mainly due to their redox properties that play an important role in absorbing and neutralizing free radicals [25]. The phenolic content found in crude extracts of selected actinomycetes was in the range of 1µg/ml to 80 µg/ml. The higher phenol content and antioxidant activity were observed in TRA-26 extract. Phenol content in antioxidant compounds is positively correlated with their antioxidant activities [26] and also acts as a key element for deciding the antioxidant efficacy of secondary metabolites [27]. The higher total antioxidant activity found in strain TRA-26 also confirmed the interdependence of phenolic content and antioxidant capacity of a secondary metabolite.
The scavenging of hydroxyl radical was more in extracts of strain TRA-21. The activities were moderate in TRA-1 and TRA-3a extracts, whereas least observed in strain TRA-46 as shown in fig. 3.
The reducing power of selected actinomycetes extracts was examined in terms of their ability to reduce Fe3+to Fe2+and the results are presented in fig.4. Of the total isolates, 11 showed the capacity to reduce ferric ion as indicated by an increase in absorbance at 700 nm over the control. The strain TRA-1 showed highest reducing power followed by TRA-26 and TRA-3. The least activity was recorded in strain TRA-12 while it was absent from strains TRA-9 and TRA-28.

Fig. 2: Phenol content and total antioxidant activity of actinomycetes isolated from C. longa root rhizosphere. Each value represents mean±SD of three independent replicates. Error bar indicates SD
The reports on metal chelation capacity of actino bacterial secondary metabolites were least found in published literature. In the present study, activity was studied in terms of chelation of iron and was found only in six extracts (fig.5). The chelation capacity was more in TRA-46 which was comparable to standard chelating agent EDTA (60%, 100 µg/ml). Iron chelators play an important role to relieve the oxidative stress generated due to iron overload. The accumulation of toxic iron concentration can cause tissue damage leading to heart failure, hyperthyroidism, liver failure and early death [28].

Fig. 3: Hydroxyl radical scavenging activity of actinomycetes isolated from C. longa root rhizosphere. Each value represents mean±SD of three independent replicates. Error bar indicates SD
Ascorbic acid (500 µg/ml) showed 80.64% radical scavenging activity

Fig. 4: Reducing the power of actinomycetes isolated from C. longa root rhizosphere. Each value represents mean±SD of three independent replicates Error bar indicates SD
The reducing activity of tannic acid (50 µg/ml) in terms of O. D.700 was 1.343

Fig. 5: Metal chelation capacity of actinomycetes isolated from C. longa root rhizosphere. Each value represents mean±SD of three independent replicates. Error bar indicates SD
Enzyme inhibitory activities of actinomycetes
The results of α-glucosidase, α-amylase and lipase inhibition assay for selected actinomycetes are shown in fig.6. The crude extract of TRA-26 showed a significant inhibition in α-glucosidase activity followed by TRA-12 and TRA-1 extracts. Similarly, the activity of α-amylase was reduced greatly in the presence of extracts of TRA-30, TRA-28 and TRA-46 respectively. α-amylase activity inhibition was moderate in TRA-1, TRA-16 and TRA-21 extracts whereas it was least observed in strain TRA-3a. The enzymes α-glucosidase and α-amylase break down the carbohydrate into absorbable monosaccharides [29]. The inhibitor of these enzymes delays the absorption of ingested carbohydrates and thus lowers the rise in blood glucose level. Hence, such compounds are good drug targets for reducing the disorders such as diabetes mellitus.
Lipases play a significant role in the development of obesity leading to type ІІ diabetes and cardiovascular diseases. Lipase inhibitors bind to intestinal lipases [30] preventing the hydrolysis of dilatory triglycerides to mono glycerides and fatty acids [31]. This reduces the absorption of fats resulting in lessened obesity. In the present study, extracts of nine isolates showed lipase inhibition activity with the highest inhibition found in the presence of TRA-9 extract (65%). Orlistat was used as a standard lipase inhibitor. Although lower than orlistat (100 µg/ml, 80.92%) and studied at primary level, the inhibition shown by TRA-9 crude extract was noticeable.
Antifungal potential
The antifungal activities of selected strains of actinomycetes are shown in table 1. Of the 14 isolates, TRA-16 and TRA-1 highly inhibited the growth of A. niger and A. flavus respectively. C. neoformans was sensitive to three isolates with the highest zone of inhibition (35 mm) produced in the presence of strain TRA-1 extract (fig.7). T. rubrum was inhibited by only one isolate with maximum inhibition (13 mm) caused by strain TRA-1.

Fig. 6: Enzyme inhibitory activities of actinomycetes isolated from C. longa root rhizosphere. Each value represents mean±SD of three independent replicates. Error bar indicates SD
Acarbose (100 µg/ml) showed 76.25% and 62.59% inhibition in α-amylase and α-glucosidase activity. Orlistat (100 µg/ml) showed 80.92% inhibition in lipase activity
Table 1: Antifungal efficacy of crude extract of selected isolates, each value represents mean±SD of three independent replicates
Isolate |
Name of the test pathogen/Zone of inhibition (mm) |
|||
A. niger |
A. flavus |
C. neoformans |
T. rubrum |
|
TRA1 |
18±1.2*(78.26) |
12±0.69(70.58) |
35±0.71(87.5) |
13±0.165(72.22) |
TRA3 |
6±0.29(54.54) |
8±0.13(61.53) |
10±0.19(66.66) |
0.00(0) |
TRA16 |
29±0.49(85.29) |
6±0.26(54.54) |
0.00(0) |
0.00(0) |
TRA21 |
14±0.83(73.68) |
0.00(0) |
0.00(0) |
0.00(0) |
TRA24 |
10±0.77(66.66) |
8±0.49(61.53) |
0.00(0) |
0.00(0) |
TRA26 |
6±1.47(54.54) |
0.00(0) |
0.00(0) |
0.00(0) |
TRA30 |
10±0.32(66.66) |
0.00(0) |
0.00(0) |
0.00(0) |
TRA54 Nystatin |
9±0.94(64.28) 22.4±0.69(76.19) |
0.00(0) 18.9±2.24(79.07) |
4±0.03(44.44) 19.3±1.75(79.42) |
0.00(0) 17.2±0.34(77.47) |
*Fig. in parenthesis represents percent antifungal activities.

Fig. 8: Phylogenetic tree based on 16S rRNA gene sequence showing taxonomic relatedness between TRA-1 and related members of genus Streptomyces
Fig. 7: Antifungal activity of TRA-1 extract against A. niger (A) and C. neoformans (B) by agar well diffusion method
Characterization of TRA-1
The actinomycetes strain TRA-1 isolated from the rhizosphere of C. longa was identified as Streptomyces genus according to its ability to form substrate and aerial mycelium and form spiral spore chains. The isolate produced colonies with light pink spore mass on SCA with pale yellow reverse. The cell wall chemo type І was designated by observing the presence of LL-Diaminopimelic acid and without any characteristic sugar pattern in cell wall hydrolysate. Further characterization of TRA-1 was done by 16S rRNA analyses. The isolate showed 99% homology with existing species of S. albus (KC441801.1). The taxonomic position of the isolate is shown in fig. 8.
CONCLUSION
In the present study 14 actinomycetes, strains associated with root rhizosphere of Curcuma longa have been screened for antioxidant, enzyme inhibitory and antifungal potential. All the isolated strains have the capacity to produce one or more biologically active substances. The potent strain Streptomyces albus TRA-1 with abilities to produce antioxidant, enzyme inhibitory and antifungal compounds could be used as a promising strain for the development of pharmaceutically important drugs.
CONFLICT OF INTERESTS
All authors have no conflict to declare.
REFERENCES
- Demain AL, Sanchez S. Microbial drug discovery: 80 y of progress. J Antibiot 2009;62:5-16.
- Blunt JW, Princep MR. Marine natural products. Nat Prod Rep2006;23:26-78.
- Ouédraogo M, Konaté K, Zerbo P, Barro N, Laya L. Phytochemical analysis and in vitro antifungal profile of bioactive fractions from Sterculia setigera (Sterculiaceae). Curr Res JBiol Sci 2013;5:75-80.
- Berdy J. Bioactive microbial metabolites. J Antibiotechnol (Tokyo)2005;58:1-26.
- Sharma SK, Gupta VK. In vitro antioxidant studies of Ficus resimosa linn root. Pharmacogn Mag 2008;13:70-4.
- Bull AT, Ward AC, Goodfellow M. Search and discovery strategies for biotechnology: the paradigm shift. Microbiol Mol Biol2000;64:573-606.
- Watve MG, Tickoo R, Jog MM, Bhole BD. How many antibiotics are produced by the genus streptomyces? Arch Microbiol2001;176:386-90.
- Pham-Huy LA, He H, Pham-Huy C. Free radicals, antioxidants in disease and health. Int J Biomed Sci 2008;4:89–96.
- Kuster E, Williams ST. Selective media for the isolation of streptomycetes. Nature 1964;202:928-9.
- Zhao GR, Xiang ZJ, Ye TX, Yaun JY, Guo XZ. Antioxidant activities of saliva miltiorrhiza and panax notoginseng. Food Chem 2006;99:767-74.
- Singleton VL, Orthofehr R, Lamuela-Raventos RM. Analysis of total phenols and other oxidation substrates and antioxidants by means of Folin-Ciocalteau reagent. Methods Enzymol 1999;299:152-78.
- Chang LW, Yen WJ, Huang SC, Duh PD. Antioxidant activity of sesame coat. Food Chem 2002;78:347-54.
- Elizabeth K, Rao MN. Oxygen radical scavenging activity of curcumin. Int J Pharm 1990;58:237-40.
- Oyaizu M. Studies on the product of browning reaction prepared from glucosamine. Japanese J Nutr 1986;44:307-15.
- Ebrahimzadeh MA, Pourmorad F, Bekhradnia AR. Iron chelating activity, phenol and flavenoid content of some medicinal plants from Iran. Afr J Biotechnol 2008;7:3188-92.
- Sathiyaseelan K, Stella D. Isolation and screening of α-glucosidase enzyme inhibitor producing marine actinobacteria isolated from pitch avaram mangrove. Int J Pharma Biol Arch 2012;3:1142-9.
- Pratibha S, Thenmozhi M, Kannabiran K. Screening of glycolytic enzyme inhibitory activity of Streptomyces isolates from brine spring and marine sediments of India. Int J Pharma Res Rev 2013;2:5-11.
- Selvam K, Visnupuria B, Bose SC. Screening and quantification of marine actinomycetes producing industrial enzymes amylase, cellulase and lipase from south coast of India. Int J Pharm Biol Arch 2010;2:1481-5.
- Kelly KL. Centroid notations for the revised ISCC-NBS color name blocks. J Res Nat BurStandardsUSA 1958;61:427.
- Hasegawa T, Takizawa M, Tanida S. A rapid analysis for chemical grouping of aerobic actinomycetes. J Gen Appl Microbiol1983;29:319-22.
- Staneck JL, Roberts GD. A simplified approach to the identification of aerobic actinomycetes by thin-layer chromatography. Appl Microbiol 1974;28:226-31.
- Kimura MA. Simple method for estimating evolutionary rates of base substitutions through comparative studies of nucleotide sequences. J Mol Evol 1980;16:111-20.
- Saitou N, Nei M. The neighbour-joining method: a new method for reconstructing phylogenetic trees. Mol Biol Evol 1987;4:406-25.
- Zhong K, Gao XL, Xu ZJ, Gao H, Fan S, Yamaguchi I, et al. Antioxidant activity of a novel Streptomyces strain Eri12 isolated from the rhizosphere of rhizoma curcumae longae. Curr Res Bacteriol 2011;4:63-72.
- Saha MR, Alam MA, Akter R, Jahangir R. In-vitro free radical scavenging activity of Ixora coccinea L. Bangladesh J Pharmacol 2008;3:90-6.
- Katalinic V, Milos M, Kulisic T, Jukic M. Screening of 70 medicinal plant extracts for antioxidant capacity and total phenols. Food Chem 2006;94:550-7.
- Markovic ZS, Manojlovic NT. Analytical characterization of lichexanthone in lichen: HPLC, UV spectroscopic and DFT analysis of lichexanthone extracted from Laurera benguelenisis (Mull. Arg.). Zahlbr Monatshefte Chemie 2010;141:945-52.
- Loukopoulos D. Combined therapy with deferiprone and desferrioxamine in thalassemia major. Hematol J 2005;90:1304-5.
- Stuart AR, Gulve EA. Chemistry and biochemistry of type 2 diabetes. Chem Rev 2004;104:1255-82.
- Franson K, Rossner S. Fat intake and food choices during weight reduction with diet, behavioural modification and a lipase inhibitor. J Int Med 2000;247:607-14.
- Yun W. Possible anti-obesity therapeutics from nature–a review. Phytochem 2010;71:1625-41.